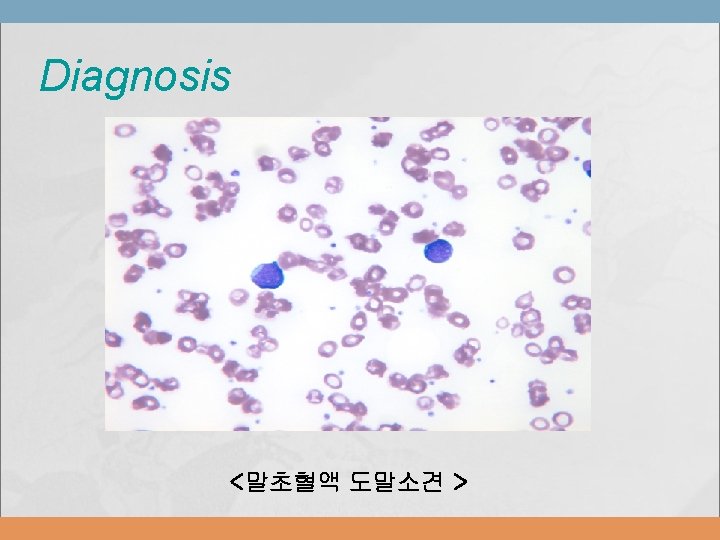
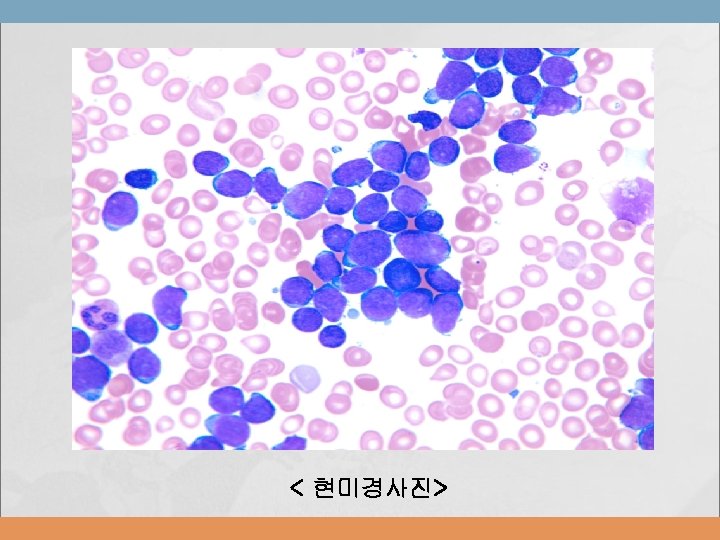

Acute leukemia in Pediatrics Young shil Park Division




















































- Slides: 52

Acute leukemia in Pediatrics Young shil, Park Division of Hematology-Oncology Department of Pediatrics Kyung Hee University Hospital at Gangdong

Introduction most common malignant neoplasms in childhood about 41% of all malignancies that occur in children younger than 15 yr of age an annual incidence of 4. 1 new cases per 100, 000 children younger than 15 yr of age


Acute Lymphoblastic Leukemia

the first disseminated cancer shown to be curable model malignancy for the principles of cancer diagnosis, prognosis, and treatment heterogeneous group of malignancies

ALL Epidemiology striking peak incidence between 2– 6 yr of age more common in children with certain chromosomal abnormalities such as Down syndrome Bloom syndrome ataxia-telangiectasia Fanconi syndrome

Etiology unknown B-cell ALL and Epstein-Barr viral infections in certain developing countries

Pathogenesis Classification • Morphology • Phenotypic characteristics ( cell membrane markers ) • Cytogenetic and molecular genetic features

FAB classification L 1 Monotonous blasts 85% of ALL L 2 More heterogeneous Prominent nucleoli 14% of ALL L 3 Large, deeply staining Vacuoles 1% of ALL the presence of surface Ig and t(8; 14)

Common Chromosomal Abnormalities in the Acute Leukemias of Childhood Chromosomal Abnormality Influence on Prognosis ALL, pre-B Trisomy 4 and 10 Favorable t(12; 21) ALL, pre-B t(4; 11) Unfavorable ALL, pre-B t(9; 22) Unfavorable ALL, B-cell t(8; 14) None ALL (general) Hyperdiploidy Favorable ALL (general) Hypodiploidy Unfavorable AML, M 1 * t(8; 21) Favorable AML, M 4 * inv(16) Favorable AML, M 3 * t(15; 17) Favorable AML (general) del(7) Unfavorable AML, infant t(4; 11) Unfavorable Disease, Subtype ALL = acute lymphoblastic leukemia; AML = acute myelogenous leukemia.

Estimated Frequency of Specific Genotypes of ALL in Children NEJM 2004; 350: 1535 -48

Estimated Frequency of Specific Genotypes of Pediatric ALL in single center in Korea, 2006, 소아과 추계


Clinical Manifestations usually nonspecific and relatively brief Anorexia, fatigue, and irritability intermittent, low-grade fever Bone or joint pain, particularly in the lower extremities physical examination • pallor, listlessness, purpuric and petechial skin lesions, or mucous • • membrane hemorrhage lymphadenopathy, splenomegaly Respiratory distress ; adolescent boys with T-cell ALL


Diagnosis strongly suggested by peripheral blood findings indicative of bone marrow failure leukemic cells ; often initially reported to be atypical lymphocytes Bone marrow aspiration / bone marrow biopsy ; more than 25% of the bone marrow cells as a homogeneous population of lymphoblasts in CSF

Pathologic findings Peripheral Smear in child with ALL: decreased platelets and no normal WBC’s Bone marrow smear blast cells must be >25%

DIFFERENTIAL DIAGNOSIS acute myelogenous leukemia (AML) neuroblastoma, Ewing's sarcoma aplastic anemia infectious mononucleosis in patients with acute onset of fever and lymphadenopathy

Treatment The single most important prognostic factor in ALL is the treatment. Survival rates of children with acute lymphoblastic leukemia treated on sequential Children's Cancer Group (COG) clinical trials over 30 yr.

the estimated clinical risk of relapse in the patient Ø the age of the patient at the time of diagnosis Ø the initial leukocyte count Ø the speed of response to treatment

ALL-Treatment older than 10 yr of age initial leukocyte count of more than 50, 000/μL specific chromosomal abnormalities such as t(9; 22) or t(4; 11)

ALL-Treatment

Remission induction eradicate the leukemic cells from the bone marrow Duration ; 4 wk vincristine, corticosteroid such as dexamethasone or prednisone, and L-asparaginase Intrathecal chemotherapy 98% of patients ; in remission • less than 5% blasts in the marrow • return of neutrophil • platelet counts to near-normal levels

Consolidation and Maintenance therapy Without additional therapy, relapse ( median of 1 to 2 months ) Postinduction therapy • Suppress leukemic growth • Continue leukemic cytoreduction without permitting the emergence of a drug-resistant clone

Consolidation • period of intensified treatment administered immediately after remission Maintenance • Combination of methotrexate and 6 -MP continuously • Intermittent pulses of vincristine and steroid Duration of treatment • 2. 5 to 3. 0 years

Supportive care tumor lysis syndrome severe myelosuppression • RBC and PLT transfusion • Hematopoietic growth factors ( G-CSF) • aggressive empirical antimicrobial therapy for sepsis in febrile children with neutropenia prophylactic treatment of Pneumocystis carinii and fungus

ALL Prognosis long-term survival, with the rate greater than 80% after 5 yr most important prognostic factor is the choice of appropriate risk-directed therapy • the type of ALL • the stage of disease • the age of the patient • the rate of response to initial therapy


Relapse Bone marrow, CNS, and testis Relapse in the bone marrow ; 15– 20% of patients Testicular relapse in 1– 2% of boys with ALL • usually after completion of therapy • painless swelling of one or both testes

ALL diagnosis Determine risk Remission induction chemotherapy Determine risk Low risk High risk Relapse Consolidation & Maintenance chemotherapy Treatment termination HLA-matched donor search Hematopoietic stem cell transplantation

Acute Myelogenous Leukemia

AML Epidemiology 11% of the cases of leukemia in childhood In Korea ; 일년에 100명 정도의 신환

AML * French-American-British (FAB) Classification of AML Subtype Common Name M 1 Acute myeloblastic leukemia without maturation M 2 Acute myeloblastic leukemia with maturation M 3 Acute promyeloblastic leukemia M 4 Acute myelomonocytic leukemia M 5 Acute monocytic leukemia M 6 Erythroleukemia M 7 Acute megakaryocytic leukemia

AML M 1 M 2 M 3

AML combination of morphologic, immunophenotypic, and cytogenetic studies



AML Clinical manifestations Due to replacement of bone marrow by malignant cells Due to secondary bone marrow failure Infiltration of the gingiva Discrete masses ( chloroma or granulocytic sarcoma )

AML Generalized inflammation and hyperplasia of the gingiva

AML chloroma

AML Acute promyelocytic leukemia most common genetic abnormality • reciprocal translocation between the PML gene at chromosome band 15 q 22 and RARα at 17 q 21 introduction of all-transretinoic acid (ATRA) as front-line therapy for APL Molecular testing for the PML-RARα fusion • Persistence or reappearance of the fusion transcript after completion of therapy -> relapse 25% of children ; relapse another 5% die of complications

AML Treatment overall survival rate ; approximately 60% Aggressive multiagent chemotherapy ; inducing remission in about 80 % of patients Matched-sibling stem cell transplantation after remission ; longterm disease-free survival in 60 -70%

AML Remission induction chemotherapy Complete remission HLA-matched donor search Consolidation chemotherapy Hematopoietic Stem cell transplantation

AML


Thank you for your attention~!